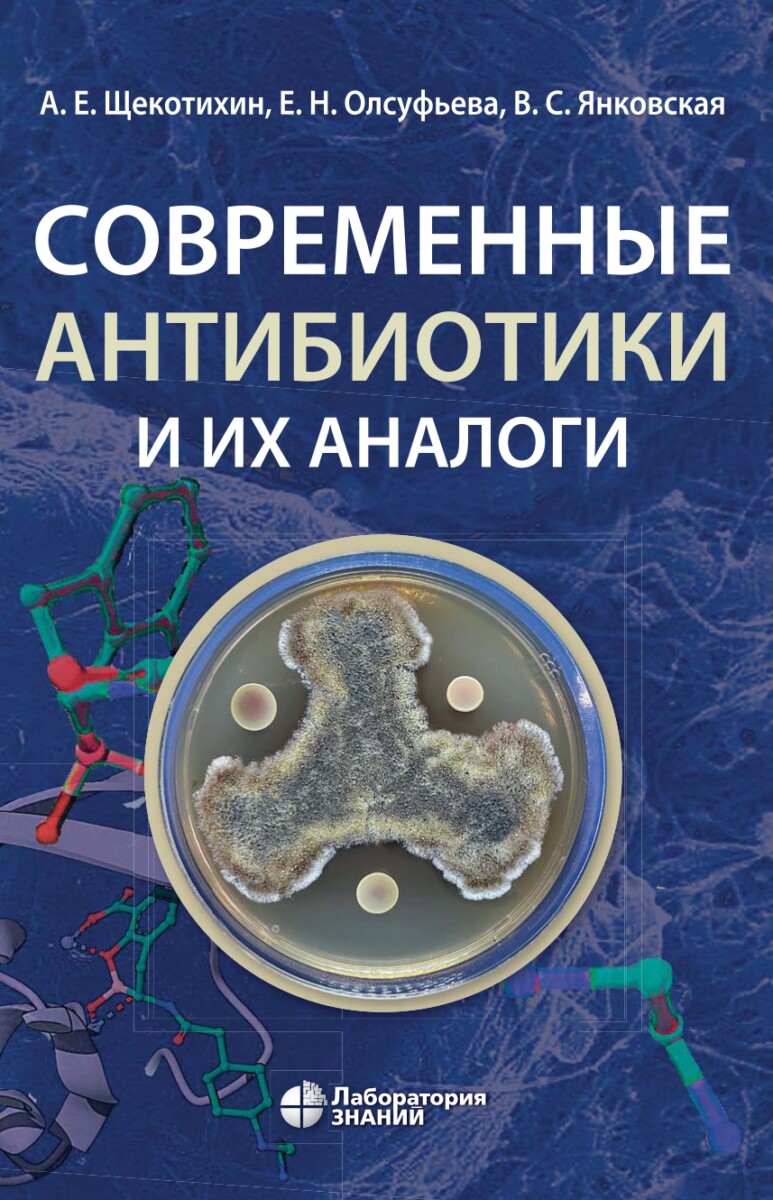

Современные антибиотики и их аналоги. 2-е изд.
2 990 ₽
В книге «Современные антибиотики и их аналоги» рассмотрены все важнейшие классы современных антибиотиков и их аналогов, начиная с истории их открытия, заканчивая обзором практического применения в медицине и хозяйстве.
Авторы монографии описали:
• основы биотехнологического и химического производства этих лекарственных препаратов,
• ключевые аспекты механизмов действия антибиотиков,
• проблемы их практического использования,
• молекулярные основы механизмов антибиотикорезистентности микроорганизмов и путей их преодоления,
• химические подходы к получению полусинтетических антибиотиков и синтетических аналогов.
В книге также затронуты вопросы контроля применения антибиотиков в сельском хозяйстве.
При написании монографии авторы старались максимально придерживаться междисциплинарного подхода и аккумулировать в ней всю ключевую базовую информацию об антибиотиках.
Книга предназначена для широкого круга научных сотрудников, преподавателей химических, биологических, медицинских и сельскохозяйственных вузов, а также студентов и аспирантов, избравших своей специальностью микробиологию, фармакологию, медицинскую или биоорганическую химию и фундаментальную медицину.
Кроме того, монография будет полезна всем специалистам, интересующимся химией и фармакологией антибиотиков.
В наличии
| Автор | Олсуфьева Е.Н., Щекотихин А.Е., Янковская В.С. |
|---|---|
| ISBN | 978-5-00101-152-1 |
| Обложка | твердая |
| Количество страниц | 622 |
| Издательство | Лаборатория знаний |
| Год издания | 2026 |